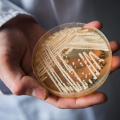
İçindeki mantarlar kanserli hücrenin büyümesine neden olabilir mi?

Murat Altaş
Nobel Fizik Ödülü’nü kazananlar belli oldu
Nobel Fizik Ödülü'nü kuantum mekanikleri konusundaki çalışmalarından ötürü Fransız fizikçi Alain Aspect, Amerikalı teorik ve deneysel fizikçi John F. Clauser ve Avusturyalı kuantum fizikçisi Anton Zei...
İçindeki mantarlar kanserli hücrenin büyümesine neden olabilir mi?
İki çalışma, kanser ve mantarlar arasında şimdiye kadarki en net bağlantıyı buldu. Birinde, araştırmacılar 35 kanser türünden 17.000'den fazla doku ve kan örneğinde mantar popülasyonlarını katalogladı...
Alzheimer ilacı adayı, klinik denemelerde bilişsel gerilemeyi azaltıyor
Alzheimera karşı bir ilaç adayının, klinik bir denemede insanlarda bilişsel gerilemeyi %27 oranında yavaşlattığı açıklandı. Tokyo'da bir ilaç şirketi olan Eisai ve Cambridge, Massachusetts'teki biyote...
Bilim insanları Nord Stream sızıntılarını araştırıyor
Araştırmacılar, Rusya'dan Almanya'ya uzanan sualtı Nord Stream gaz boru hatlarındaki gizemli sızıntıları araştırmak için acele ediyorlar. Nord Stream 2, Rusya'nın Şubat ayında Ukrayna'yı işgal etmesin...
Ay’da ‘çay molası’, sonra hadi Mars’a
İnsanoğlunun Ay’a ilk ayak basışının üzerinden 50 yıldan uzun bir süre geçti. Bu kadar uzun bir aradan sonra başta ABD, Çin ve Rusya olmak üzere bazı ülkeler ve özel girişimciler Ay’a gitmek için yeni...
HBT Dergi 339. sayı – 29 Eylül 2022
İnsanoğlu 50 yıl aradan sonra yeniden Ay’a gidiyor Toplum kültürü ve kent mekanının oluşumu - Doğan Kuban Bir üniversite nasıl imha edilir? - Lale Akarun Muhteşem gökkuşağı - Tanol Türkoğlu “Altılı ma...